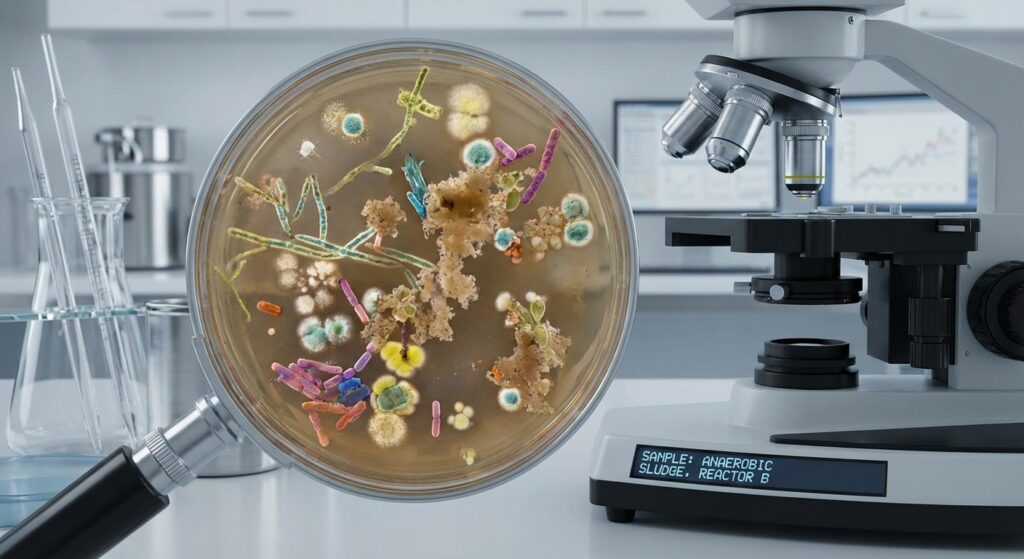
Bakterijos nuotekų valymui mikroorganizmų vaizdas po mikroskopu

Aerobinės bakterijos ir jų funkcija
Aerobinės bakterijos atlieka skaidymo procesus, kuriems reikalingas deguonis, jos efektyviai skaido organines medžiagas ir valo vandenį.
- Reikalauja deguonies
- Skatina organinių medžiagų skaidymą
Biologinis nuotekų valymas įtraukia gyvų mikroorganizmų, ypač bakterijų, veiklą, kurie natūraliu būdu skaido organines medžiagas.
Šiame straipsnyje aptarsime bakterijų vaidmenį biologiniuose nuotekų valymo procesuose, atskleisime pagrindinius mikroorganizmus ir faktorius, kurie daro įtaką efektyvumui.
Sužinokite, kaip tinkamas bakterijų palaikymas gali įtakoti valymo žingsnius ir kodėl biologinis valymas yra viena iš geriausių nuotekų valymo technologijų.
Biologinis nuotekų valymas yra procesas, kurio metu bakterijos ir kiti mikroorganizmai skaido ir įvairina organines bei kai kurias chemines medžiagas nuotekose, taip sumažindami teršalų kiekį ir apsaugodami aplinką.


Biologiniame nuotekų valyme dažniai keli mikroorganizmų tipai, iš kurių svarbiausios aerobinės ir anaerobinės bakterijos, taip pat fakultatyvinės bakterijos, kurios prisitaiko prie skirtingų sąlygų.

Aerobinės bakterijos atlieka skaidymo procesus, kuriems reikalingas deguonis, jos efektyviai skaido organines medžiagas ir valo vandenį.

Anaerobinės bakterijos gyvuoja be deguonies, jos svarbios sąvartyne ir užterštų nuotekų skaidyme, dažnai palaiko metano gamybos procesus.

Fakultatyvinės bakterijos gali prisitaikyti prie skirtingų sąlygų, jas labiausiai naudoja valymo įrenginiai, kur būtina lanksčiai reaguoti į aplinkos pokyčius.
Bakterijos nuotekų valymui veikia biologinius procesus per fermentų gamybą, kurie skaido organines medžiagas į paprastas molekules, tokias kaip anglies dioksidas, vanduo ir azoto junginiai.


Biologiniai procesai nuotekų valyme yra jautrūs įvairiems aplinkos veiksniams, kurie gali paveikti bakterijų aktyvumą, augimą ir efektyvumą.
Palaikyti tinkamas sąlygas ir reguliariai prižiūrėti nuotekų valymo įrenginius yra būtina efektyviai bakterijų veiklai ir biologinių procesų stabilumui.


Biologinis nuotekų valymas turi daug privalumų, tačiau susiduria ir su tam tikrais iššūkiais, priklausančiais nuo bakterijų veiklos aplinkos veiksnių ir teršalų pobūdžio.
Bakterijos nuotekų valymui yra nepakeičiami biologiniai elementai, kurie efektyviai skaido teršalus ir palaiko natūralų vandens ciklą. Išlaikant tinkamas sąlygas ir prižiūrint bakterijų populiaciją, biologiniai procesai veikia efektyviai ir tvariai.
Norėdami sužinoti daugiau apie nuotekų valymo įrenginius ir sprendimus, apsilankykite Septikas.lt.
Aerobinės bakterijos skaido teršalus esant deguoniui, o anaerobinės veikia be deguonies, kartu užtikrindamos efektyvų nuotekų valymą skirtingose fazėse.
Optimalus temperatūros diapazonas yra apie 20-35 °C, kuris užtikrina bakterijų aktyvų darbą ir gerą valymo efektyvumą.